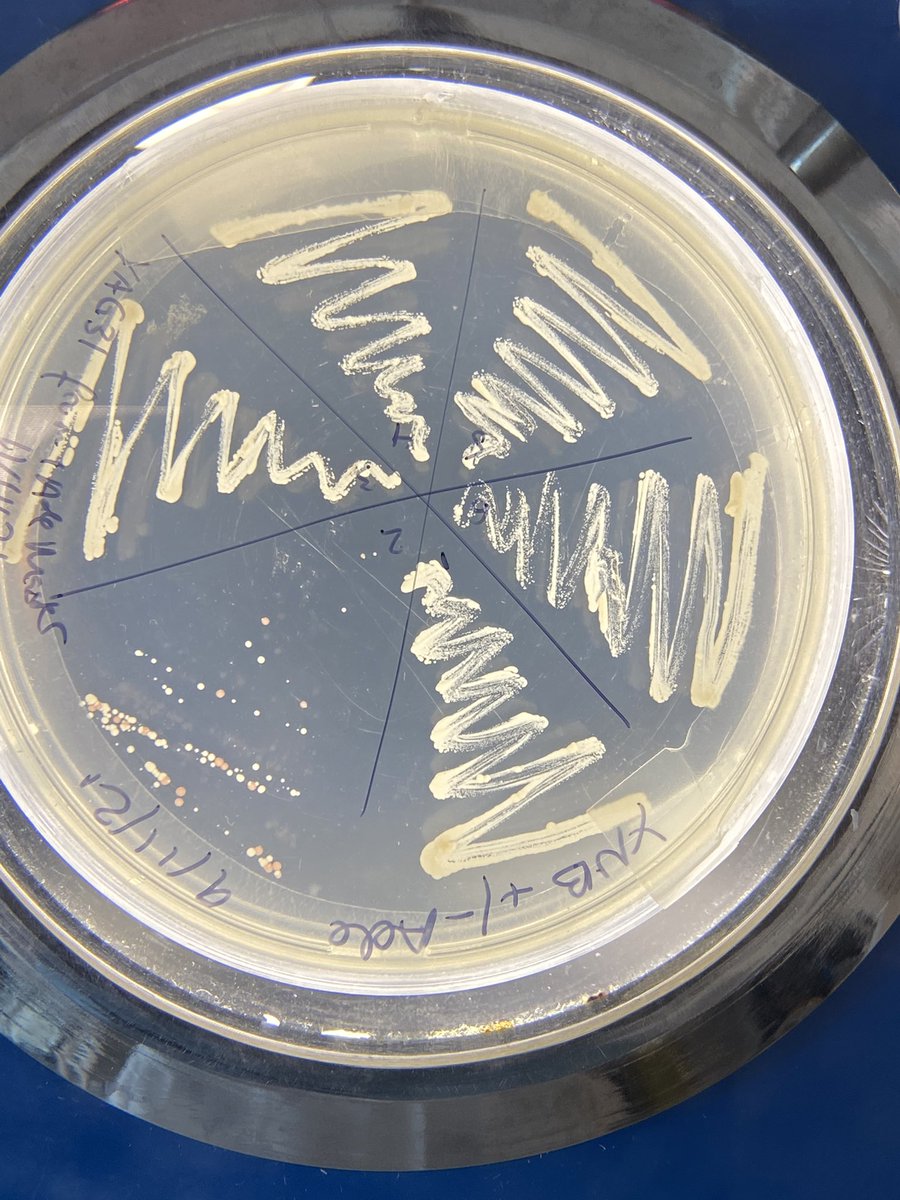
We have Xmas trees and we have baubles! Who wants to help with decorations? 

🧫: <a href="/omgfionawolf/">fenona</a> 
🦠: Saccharomyces cerevisiae

Ganley Lab
@ganleylab
Lab headed by Dr. Austen Ganley @AucklandUni, researching ribosomal DNA, random DNA and conducting acoustic experiments on Saccharomyces cerevisiae yeast.
ID: 1351084197671272451
18-01-2021 08:29:25
57 Tweet
93 Takipçi
70 Takip Edilen

What’s brewing?? Alastair Harris is busy testing the alcohol content of his micro ferments.


With Auckland currently in lockdown, no one from the lab is able to access their experiments University of Auckland | Waipapa Taumata Rau, so some of us are making Lab magazine covers on BioRender Academic Chatter™ Faculty of Science, University of Auckland










We are super stoked to have our lab head Dr. Austen Ganley presenting a talk, and Emma Macdonald Emma Macdonald (Research Assistant) and Atharva Bhide @Gloomy_Halloumi (Masters student) presenting their research posters at FAOBMB2021!!


High-level gene expression patterns in hybrid species are consistent across fungi, plants and animals, reflecting common responses to hybridisation regardless of species or even kingdom #openaccess David Winter Ganley Lab 👉ow.ly/qhhK50JY1R0